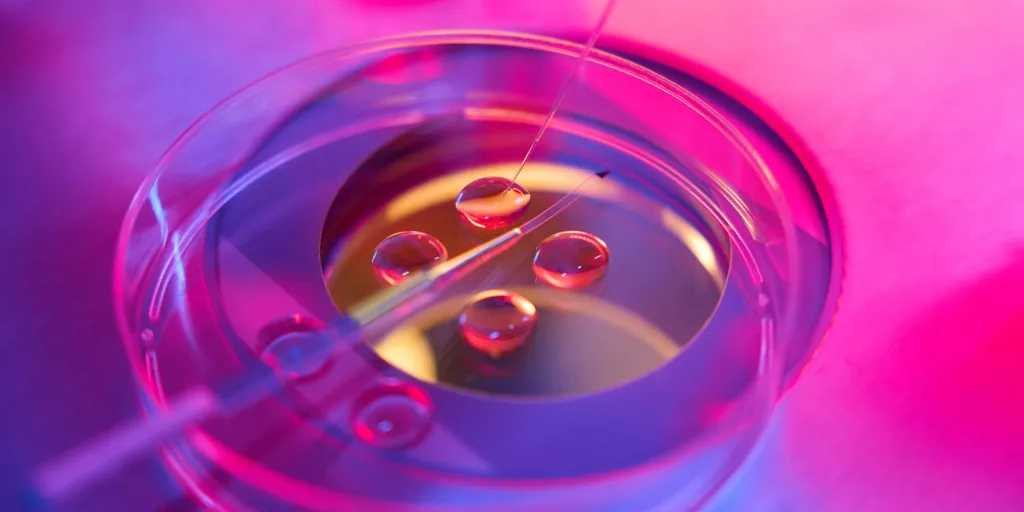
Today

Today’s Insights on the Best Age for Women to Freeze Eggs
Today’s Best Age for Women to Freeze Eggs
Today, women are navigating choices around egg freezing as they consider future family planning. Aging can heavily impact fertility, and many are asking, when does fertility decline? According to Dr. Lucky Sekhon, it's ideal to freeze eggs in your late 20s to early 30s to maintain optimal quality.
Understanding Fertility Decline
Women in their 20s have about a 20% chance of pregnancy per cycle without concerns. This rate drops to less than 5% by age 40. It’s crucial to recognize that while women are waiting longer to have children, biological factors remain unchanged. Experts stress the importance of early action.
Egg Freezing: A Smart Choice Today
- When freezing eggs in your 20s, the risk of abnormal embryos is around 20-25%.
- This rises to 30% in your mid-30s and 50-70% as you approach 40.
- Understanding the egg freezing process can demystify what many view as a daunting decision.
Today’s insights on fertility preservation highlight the importance of not waiting too long, as biological clocks continue to tick. Consult with a reproductive specialist to discuss options and timelines.
Disclaimer: The information provided on this site is for informational purposes only and is not intended as medical advice. We are not responsible for any actions taken based on the content of this site. Always consult a qualified healthcare provider for medical advice, diagnosis, and treatment. We source our news from reputable sources and provide links to the original articles. We do not endorse or assume responsibility for the accuracy of the information contained in external sources.
This article was prepared using information from open sources in accordance with the principles of Ethical Policy. The editorial team is not responsible for absolute accuracy, as it relies on data from the sources referenced.